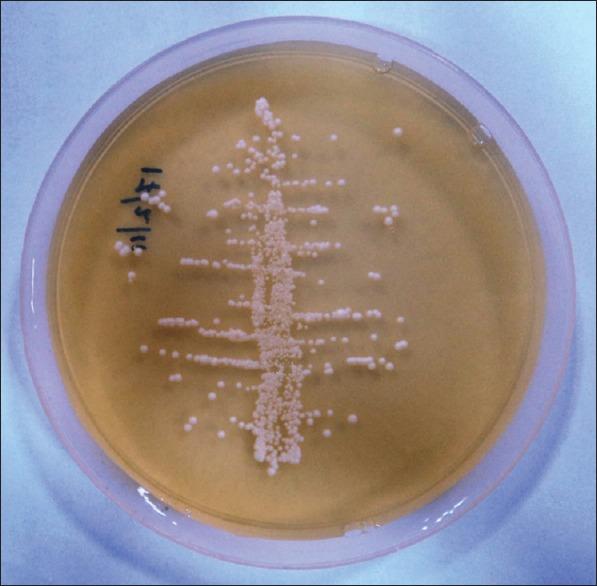

口干症患者唾液流速与念珠菌计数之间的关系。
A relationship between salivary flow rates and Candida counts in patients with xerostomia.
作者信息
Nadig Suchetha Devendrappa, Ashwathappa Deepak Timmasandra, Manjunath Muniraju, Krishna Sowmya, Annaji Araleri Gopalkrishna, Shivaprakash Praveen Kunigal
机构信息
Department of Oral Medicine and Radiology, Sri Siddhartha Dental College and Hospital, Tumakuru, Karnataka, India.
Department of Oral and Maxillofacial Pathology, Sri Siddhartha Dental College and Hospital, Tumakuru, Karnataka, India.
出版信息
J Oral Maxillofac Pathol. 2017 May-Aug;21(2):316. doi: 10.4103/jomfp.JOMFP_231_16.
CONTEXT
Most of the adult population is colonized by Candida in their oral cavity. The process of colonization depends on several factors, including the interaction between Candida and salivary proteins. Therefore, salivary gland hypofunction may alter the oral microbiota and increase the risk for opportunistic infections, such as candidiasis. Hence, it is necessary to evaluate the relationship between salivary flow rates (SFRs) and Candida colony counts in the saliva of patients with xerostomia.
AIMS
This study aims to determine and evaluate the relationship between SFRs and Candida colony forming units (CFUs) in patients with xerostomia.
SETTINGS AND DESIGN
This study was a descriptive study.
SUBJECTS AND METHODS
The study participants were taken from the patients attending outpatient department in a private dental college. Fifty patients, who reported xerostomia in a questionnaire of the symptoms of xerostomia, were selected. Chewing stimulated whole saliva samples were collected from them and their SFRs were assessed. Saliva samples were inoculated in the Sabouraud dextrose agar culture media for 24-48 h, and Candida CFUs were counted.
STATISTICAL ANALYSIS USED
Chi-squared test was used to analyze the data.
RESULTS
There was a significant inverse relationship between salivary flow and candida CFUs count when patients with high colony counts were analyzed (cutoff point of 400 or greater CFU/mL). Females had less SFR than males. Most of the patients who had hyposalivation were taking medication for the underlying systemic diseases. was the most frequent species.
CONCLUSIONS
There was a significantly negative correlation between SFRs and Candida CFUs in the patients with xerostomia.
背景
大多数成年人口的口腔中都有念珠菌定植。定植过程取决于多种因素,包括念珠菌与唾液蛋白之间的相互作用。因此,唾液腺功能减退可能会改变口腔微生物群,并增加机会性感染(如念珠菌病)的风险。因此,有必要评估口干症患者的唾液流速(SFR)与唾液中念珠菌菌落计数之间的关系。
目的
本研究旨在确定和评估口干症患者的SFR与念珠菌菌落形成单位(CFU)之间的关系。
设置与设计
本研究为描述性研究。
对象与方法
研究参与者来自一所私立牙科学院门诊部的患者。选择了50名在口干症状问卷中报告有口干症的患者。从他们那里收集咀嚼刺激后的全唾液样本,并评估其SFR。将唾液样本接种在沙氏葡萄糖琼脂培养基中培养24 - 48小时,然后计数念珠菌CFU。
所用统计分析方法
采用卡方检验分析数据。
结果
当分析高菌落计数患者(临界值为400 CFU/mL或更高)时,唾液流速与念珠菌CFU计数之间存在显著的负相关关系。女性的SFR低于男性。大多数唾液分泌减少的患者正在服用治疗基础全身性疾病的药物。 是最常见的菌种。
结论
口干症患者的SFR与念珠菌CFU之间存在显著的负相关。